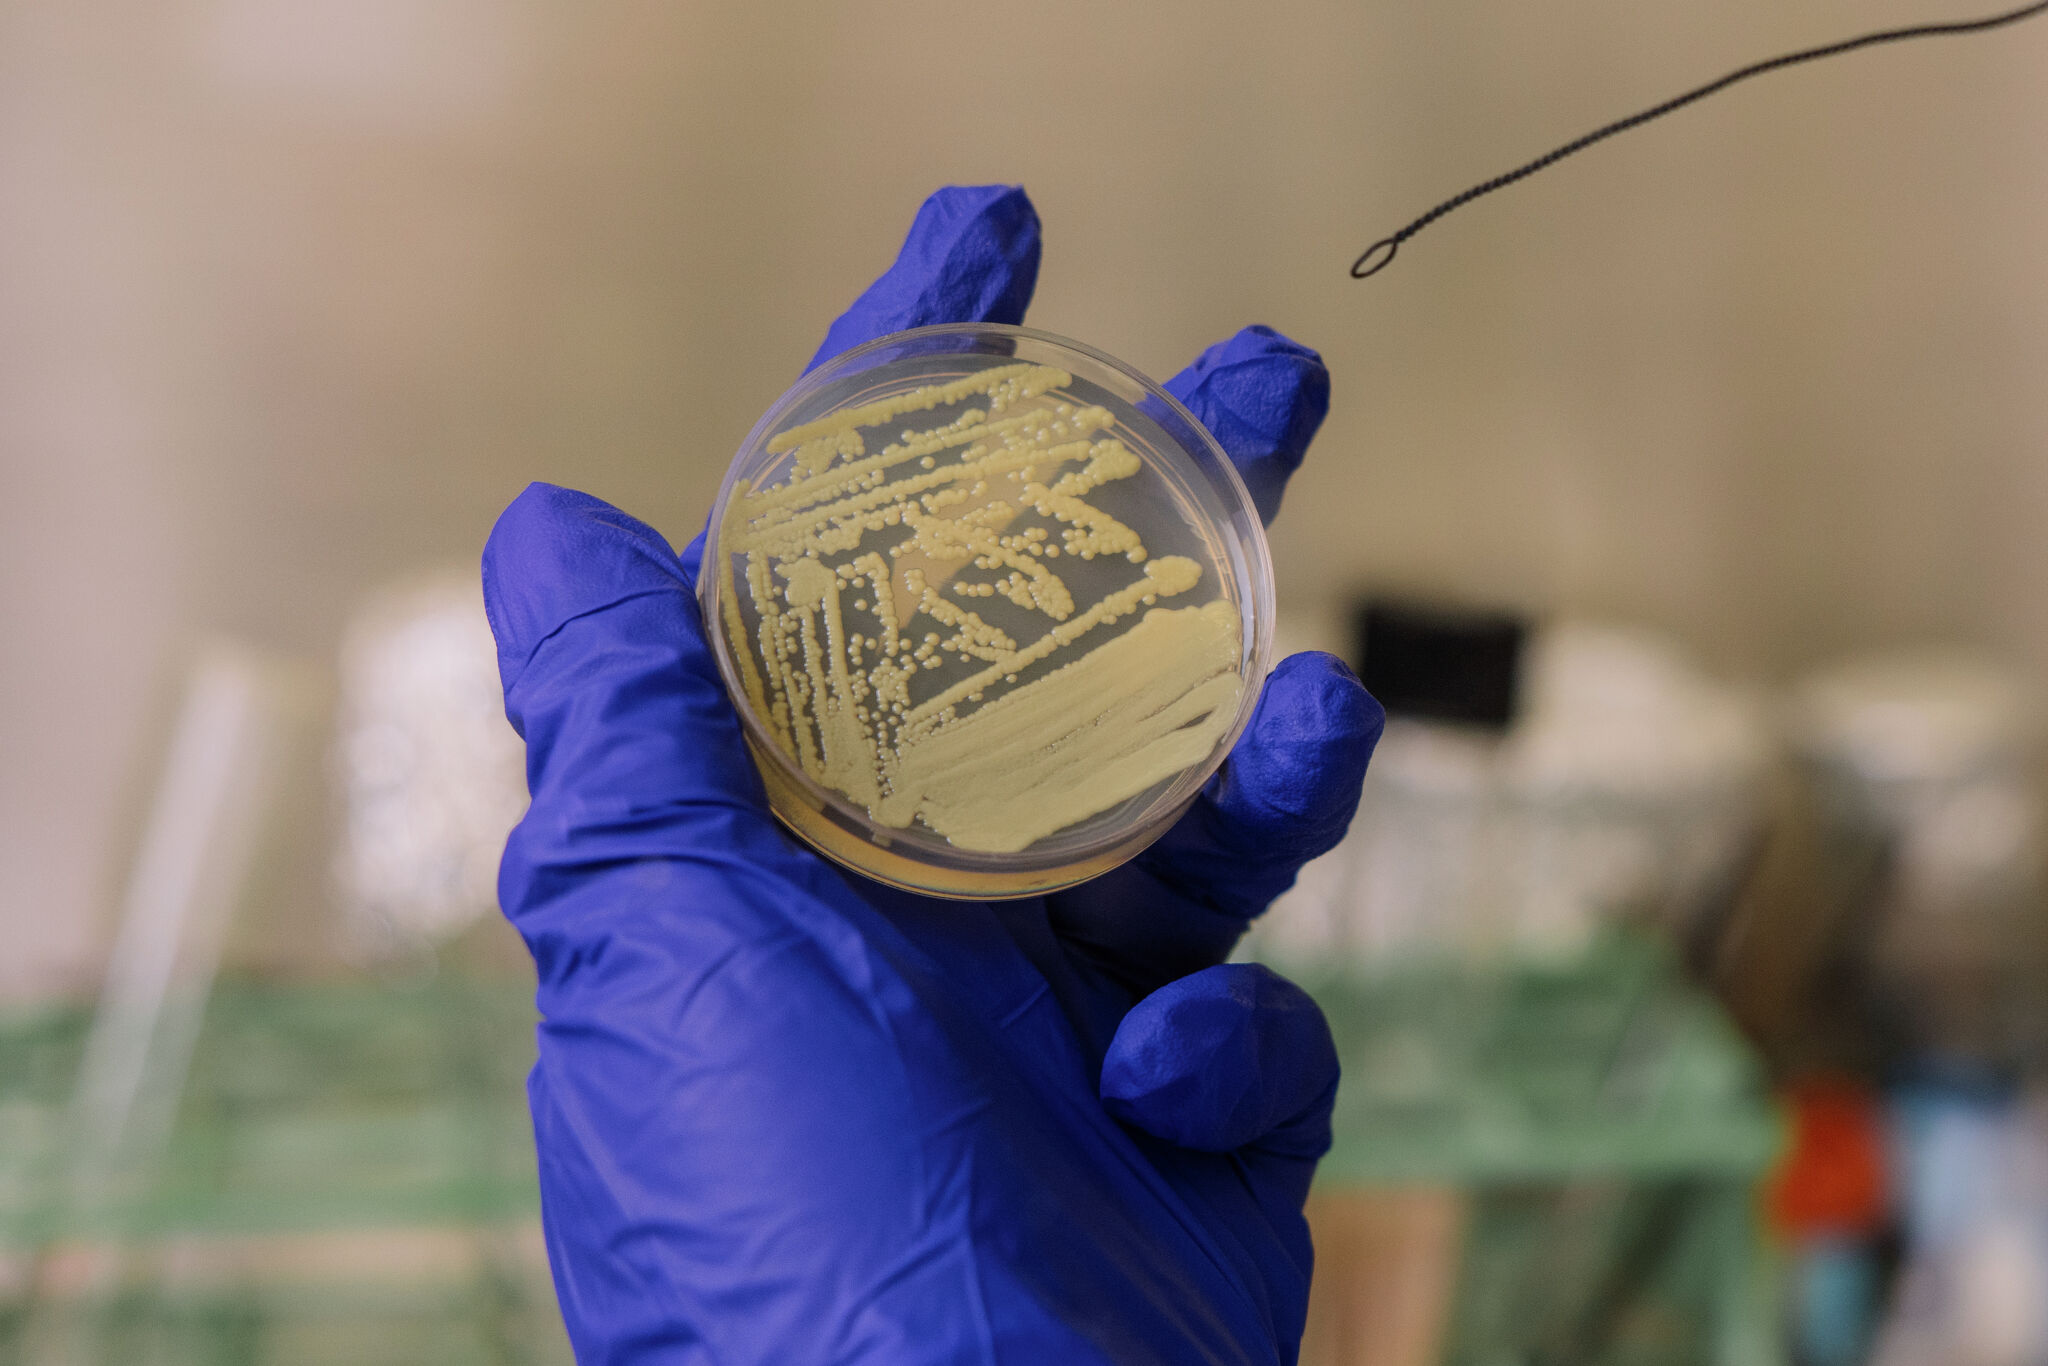

Is there a new 'South Park' episode this week? See show's schedule.
- Posted on October 21, 2025
- By The Arizona Republic
- 5 Views

Is there a new 'South Park' episode this week? See show's schedule.

Here’s what to know about Episode 2 of Season 28 of "South Park" and how to watch.